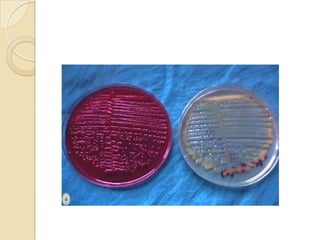
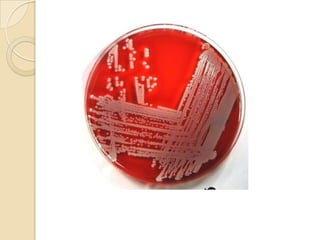
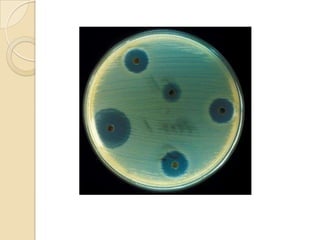

Este documento resume información sobre varias enfermedades transmitidas por alimentos, incluyendo botulismo, salmonelosis, yersiniosis, intoxicación por estafilococos, infección por E. coli y shigelosis. Describe los agentes causales, síntomas, tratamientos y medidas de prevención para cada enfermedad.